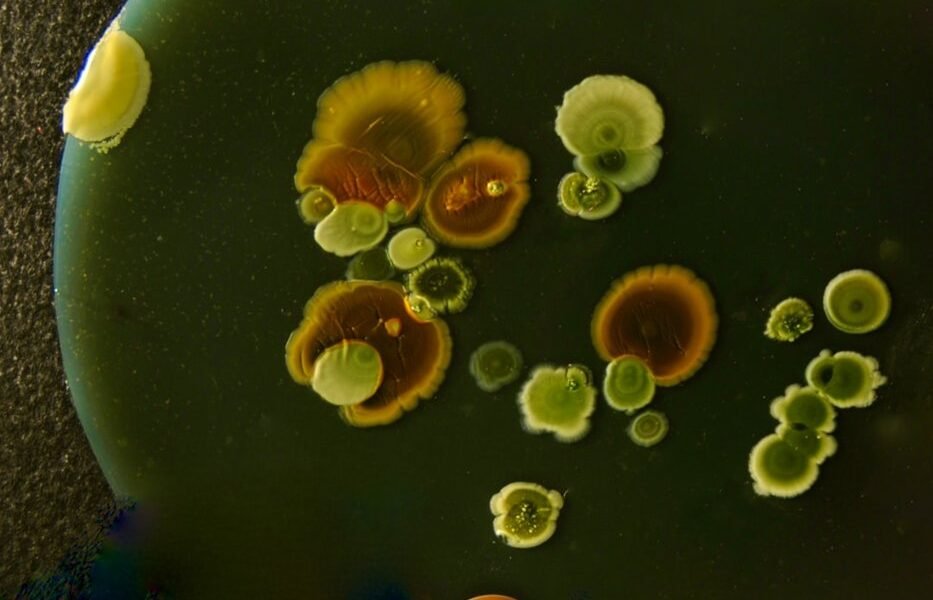
Investigación científica en pausa: el impacto de despidos en institutos de salud

Cambios en la política científica estadounidense generan preocupación internacional
Estados Unidos atraviesa un momento de transformación en su política de investigación científica que ha generado especulación y preocupación tanto dentro como fuera de sus fronteras. Reportes recientes documentan la salida de profesionales vinculados a instituciones de investigación federal, abriendo interrogantes sobre el futuro de múltiples proyectos científicos en curso y sus implicaciones para la salud pública global.
Décadas de consenso político quebrantado
Durante más de cincuenta años, el financiamiento de instituciones dedicadas a la investigación biomédica ha mantenido un nivel de apoyo bipartidista prácticamente inquebrantable en Washington. Esta estabilidad presupuestaria permitió que científicos estadounidenses desarrollaran investigaciones de largo plazo, frecuentemente con impacto internacional. Sin embargo, este patrón histórico de continuidad ha comenzado a modificarse, alterando un equilibrio que parecía consolidado.
La consistencia en el apoyo financiero a estas instituciones había sido considerada uno de los pocos temas de acuerdo genuino en la política estadounidense contemporánea. Legisladores de diferentes orientaciones políticas respaldaban tradicionalmente aumentos presupuestarios, reconociendo la importancia estratégica de mantener competitividad en investigación biomédica a nivel mundial.
Proyectos inconclusos y su alcance
Cuando investigadores abandonan sus posiciones en laboratorios federales, particularmente durante fases críticas de investigación, emergen preocupaciones concretas sobre continuidad. Estudios clínicos en desarrollo, análisis epidemiológicos multisueños y investigaciones sobre enfermedades infecciosas pueden enfrentar interrupciones que afecten su validez científica y utilidad clínica.
Estos proyectos frecuentemente cuentan con participación internacional, incluyendo colaboradores de América Latina. Universidades y centros de investigación en países como México, Brasil, Argentina y Colombia mantienen alianzas con instituciones estadounidenses, lo que significa que alteraciones en la investigación norteamericana tienen repercusiones regionales directas.
Perspectiva latinoamericana del panorama
Para la región latinoamericana, cualquier disminución en la capacidad investigativa estadounidense representa implicaciones múltiples. Muchas instituciones académicas locales dependen de financiamiento colaborativo, acceso a bases de datos estadounidenses, y capacitación de personal en centros de excelencia estadounidenses. Una reducción en actividad investigativa afecta estas oportunidades.
Adicionalmente, investigaciones sobre enfermedades prevalentes en América Latina —dengue, chagas, tuberculosis resistente— frecuentemente involucran colaboración con laboratorios estadounidenses. La interrupción de estos trabajos ralentiza avances terapéuticos que podrían beneficiar a poblaciones vulnerables en la región.
Incertidumbre institucional y retención de talento
Los cambios administrativos y políticos generan incertidumbre laboral que afecta la permanencia de científicos en instituciones federales. Profesionales experimentados pueden optar por relocalizarse en universidades privadas o en el extranjero, representando una fuga de capital humano calificado. Este fenómeno ha sido documentado históricamente tras cada cambio administrativo significativo en Washington.
La retención de investigadores es fundamental porque el conocimiento acumulado, las redes de colaboración y la experiencia institucional no se transfieren fácilmente. Cuando un investigador experimentado se retira, se pierden años de aprendizaje incremental que no pueden replicarse rápidamente.
Contexto de competencia global
La investigación biomédica opera en contexto de competencia internacional creciente. Instituciones en China, Europa y otros países destinan recursos significativos a áreas como inmunología, oncología y enfermedades infecciosas. Estados Unidos ha mantenido liderazgo histórico parcialmente por continuidad institucional y estabilidad presupuestaria. Alteraciones en este modelo podrían modificar equilibrios de poder científico global.
Proyectos específicos en riesgo
Aunque no todos los detalles de proyectos específicos afectados son públicos, investigaciones en epidemiología comparada, farmacocinética de nuevos antibióticos, y estudios sobre respuesta inmunológica a vacunas representan áreas donde interrupciones son particularmente perjudiciales. Estos trabajos requieren seguimiento longitudinal, manchas de laboratorio estables y equipo humano consistente.
Perspectivas futuras
Las próximas semanas determinarán si los cambios son puntuales o representan una reorientación más profunda. La comunidad científica internacional permanece atenta, particularmente porque cualquier decisión en Washington con implicaciones para investigación tiene efectos concéntricos que se expanden hacia instituciones académicas globales.
Para América Latina, esto subraya la importancia de fortalecer capacidades de investigación local, reducir dependencia de financiamiento externo, y construir colaboraciones sur-sur que complementen alianzas con el norte. La autonomía científica regional se vuelve progresivamente más relevante en contextos de incertidumbre política internacional.
Información basada en reportes de: Kffhealthnews.org